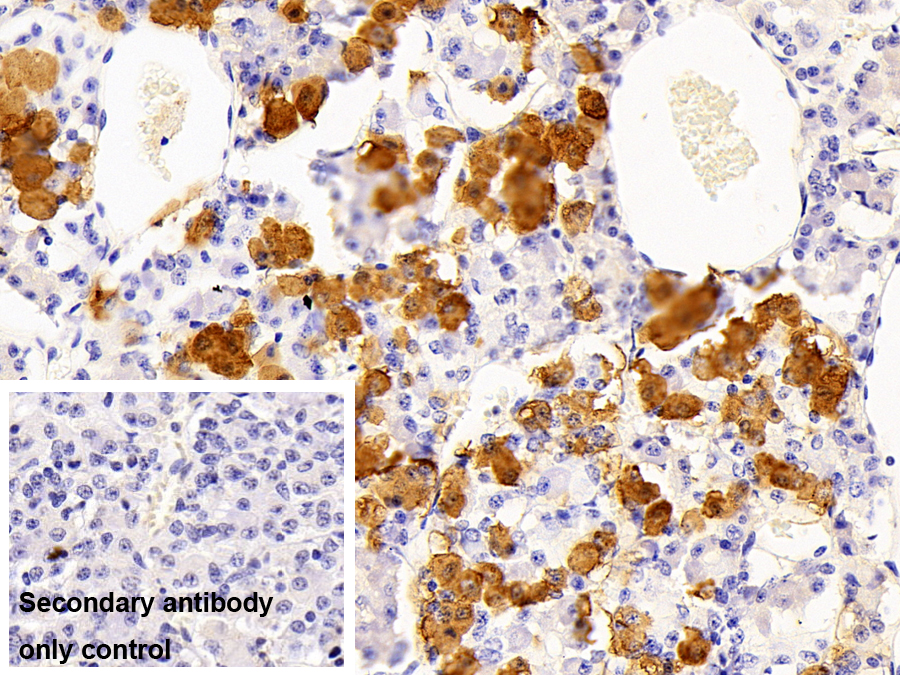
Polyclonal Antibody to Beta-Endorphin (bEP)

Polyclonal Antibody to Beta-Endorphin (bEP)
b-EP
- Product No.PAA806Hu08
- Organism SpeciesHomo sapiens (Human) Same name, Different species.
- SourcePolyclonal antibody preparation
- HostRabbit
- Potencyn/a
- Ig Type IgG
- PurificationAntigen-specific affinity chromatography followed by Protein A affinity chromatography
- LabelNone
- Immunogen n/a
- Buffer FormulationPBS, pH7.4, containing 0.02% NaN3, 50% glycerol.
- TraitsLiquid
- Concentration500µg/mL
- Organism Species MoreSus scrofa; Porcine (Pig)
- ApplicationsIHC
If the antibody is used in flow cytometry, please check FCM antibodies. - Downloadn/a
- UOM 20µl100µl 200µl 1ml 10ml
- FOB
US$
US$
US$
US$
US$
For more details, please contact local distributors!
SPECIFITY
The antibody is a rabbit polyclonal antibody raised against bEP. It has been selected for its ability to recognize bEP in immunohistochemical staining and western blotting.
USAGE
Western blotting: 0.1-2µg/mL;
Immunohistochemistry: 5-20µg/mL;
Immunocytochemistry: 5-20µg/mL;
Optimal working dilutions must be determined by end user.
STORAGE
Store at 4°C for frequent use. Stored at -20°C in a manual defrost freezer for two year without detectable loss of activity. Avoid repeated freeze-thaw cycles.
STABILITY
The thermal stability is described by the loss rate. The loss rate was determined by accelerated thermal degradation test, that is, incubate the protein at 37°C for 48h, and no obvious degradation and precipitation were observed. The loss rate is less than 5% within the expiration date under appropriate storage condition.
GIVEAWAYS
INCREMENT SERVICES
| Magazine | Citations |
| Experimental Dermatology | Endogenous μ-opioid peptides modulate immune response towards malignant melanoma Publish: RD10279 |
| European Journal of Physiology | Physiology and cell biology of acupuncture observed in calcium signaling activated by acoustic shear wave SpringerLink: tv015l3126833315 |
| International Journal of Pharmaceutical Science Invention ISSN(Online) | Effect of Ramadan fasting on endorphin and endocannabinoid level in serum, PBMC and macrophage Ijpsi: Source |
| Neurological Sciences | Evaluation of immune parameters in chronic migraine with medication overuse Pubmed:24867859 |
| Brain Behav. | Cerebrospinal fluid and plasma b-endorphin levels in children with cerebral malaria. pubmed:28413714 |
| Journal of Cosmet Dermatol. | Ultraviolet A photosensitivity profile of dexchlorpheniramine maleate and promethazine-based creams: Anti-inflammatory,antihistaminic, and skin barrier protection properties DOI: 10.1111/jocd.12349 |
| International Journal of Nursing Practice | Non‐pharmacological interventions during childbirth for pain relief, anxiety, and neuroendocrine stress parameters: A randomized controlled trial Pubmed:29512230 |
| КОРРЕКЦИЯ ЦИТОКИНОВОГО И ГОРМОНАЛЬНОГО ДИСБАЛАНСА ПРИ ЛЕЧЕНИИ СТАБИЛЬНОЙ СТЕНОКАРДИИ НАПРЯЖЕНИЯ 10.25207:1608-6228-2018-25-3-51-55 | |
| Journal of Pediatric Neurosciences | Plasma and cerebrospinal fluid beta-endorphin levels show a strong association in children with cerebral malaria |
| Chinese Journal of Physiology | Blood dopamine level enhanced by caffeine in men after treadmill running Pubmed: 31793465 |
| Free Radical Biology and Medicine | Blue light (λ= 453 nm) nitric oxide dependently induces β-endorphin production of human skin keratinocytes in-vitro and increases systemic β-endorphin levels in … Pubmed: 31553937 |
| Journal of Sexual Medicine | Between pleasure and pain: a pilot study on the biological mechanisms associated with BDSM interactions in dominants and submissives Pubmed: 32044259 |
| JOURNAL OF AFFECTIVE DISORDERS | Pain Sensitivity and Plasma Beta-Endorphin in Adolescent Non-Suicidal Self-Injury Pubmed: 32961416 |
| EUROPEAN NEUROPSYCHOPHARMACOLOGY | Serum β-endorphin levels are associated with addiction to suicidal behavior: a pilot study Pubmed: 32855024 |
| J Burn Care Res | Efficacy of Acupuncture on Pain Mechanisms, Inflammatory Responses, and Wound Healing in the Acute Phase of Major Burns: An Experimental Study on Rats 34309681 |
| European Journal of Integrative Medicine | Effects of transcutaneous electrical nerve stimulation applied at different frequencies during labor on hormone levels, labor pain perception, and anxiety: a randomized … |
| Catalog No. | Related products for research use of Homo sapiens (Human) Organism species | Applications (RESEARCH USE ONLY!) |
| CPA806Hu21 | OVA Conjugated Beta-Endorphin (bEP) | Immunogen; SDS-PAGE; WB. |
| PAA806Hu01 | Polyclonal Antibody to Beta-Endorphin (bEP) | IHC |
| PAA806Hu08 | Polyclonal Antibody to Beta-Endorphin (bEP) | IHC |
| LAA806Hu71 | Biotin-Linked Polyclonal Antibody to Beta-Endorphin (bEP) | WB; IHC; ICC. |
| CEA806Hu | ELISA Kit for Beta-Endorphin (bEP) | Enzyme-linked immunosorbent assay for Antigen Detection. |
| CCA806Hu | CLIA Kit for Beta-Endorphin (bEP) | Chemiluminescent immunoassay for Antigen Detection. |
| LMA806Hu | Multiplex Assay Kit for Beta-Endorphin (bEP) ,etc. by FLIA (Flow Luminescence Immunoassay) | FLIA Kit for Antigen Detection. |
| KSA806Hu11 | ELISA Kit DIY Materials for Beta-Endorphin (bEP) | Main materials for "Do It (ELISA Kit) Yourself". |